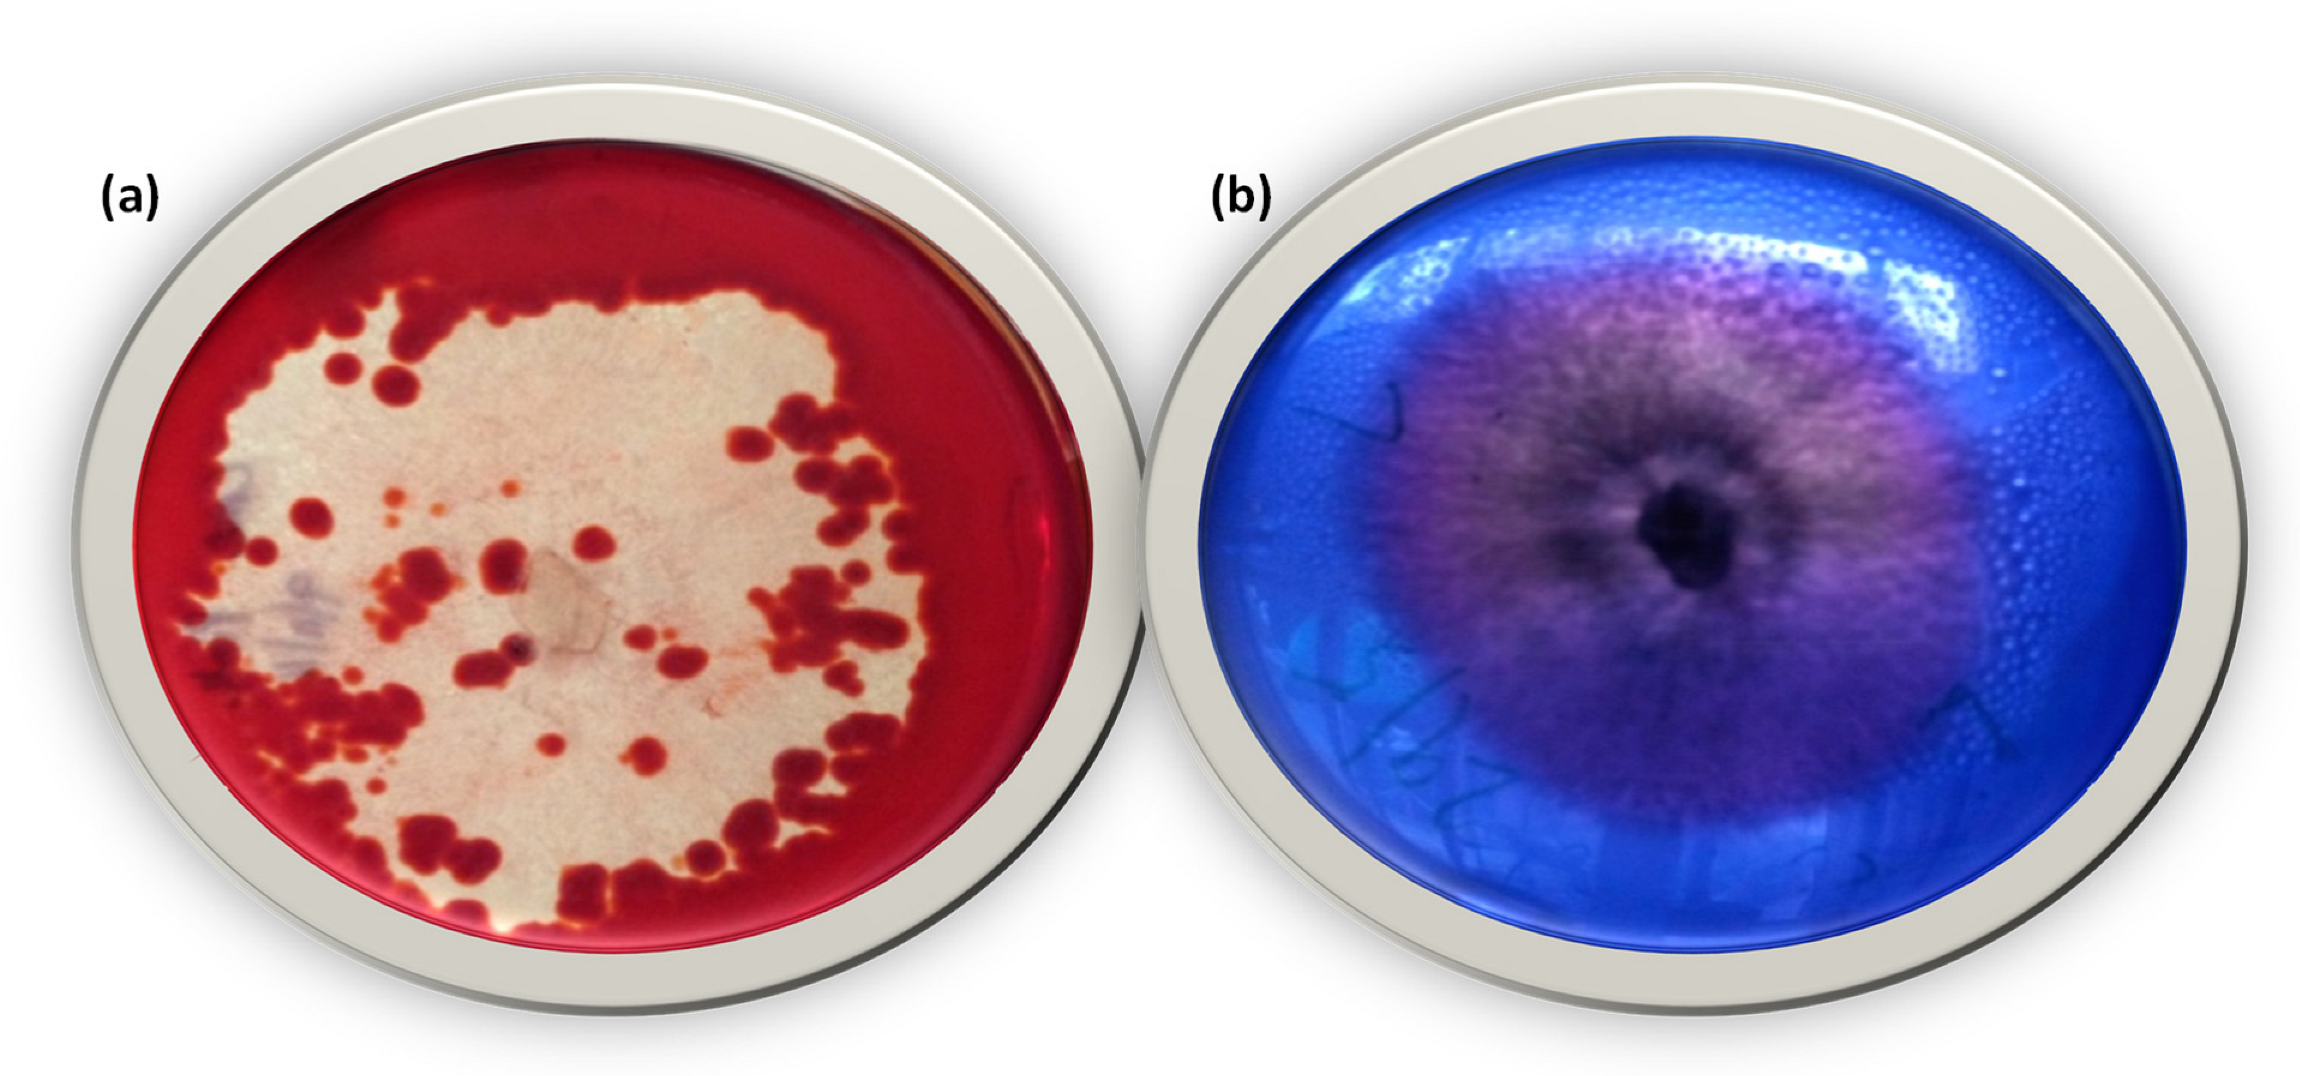
Microorganisms 11 01435 g004 Microorganisms 11 01435 g004
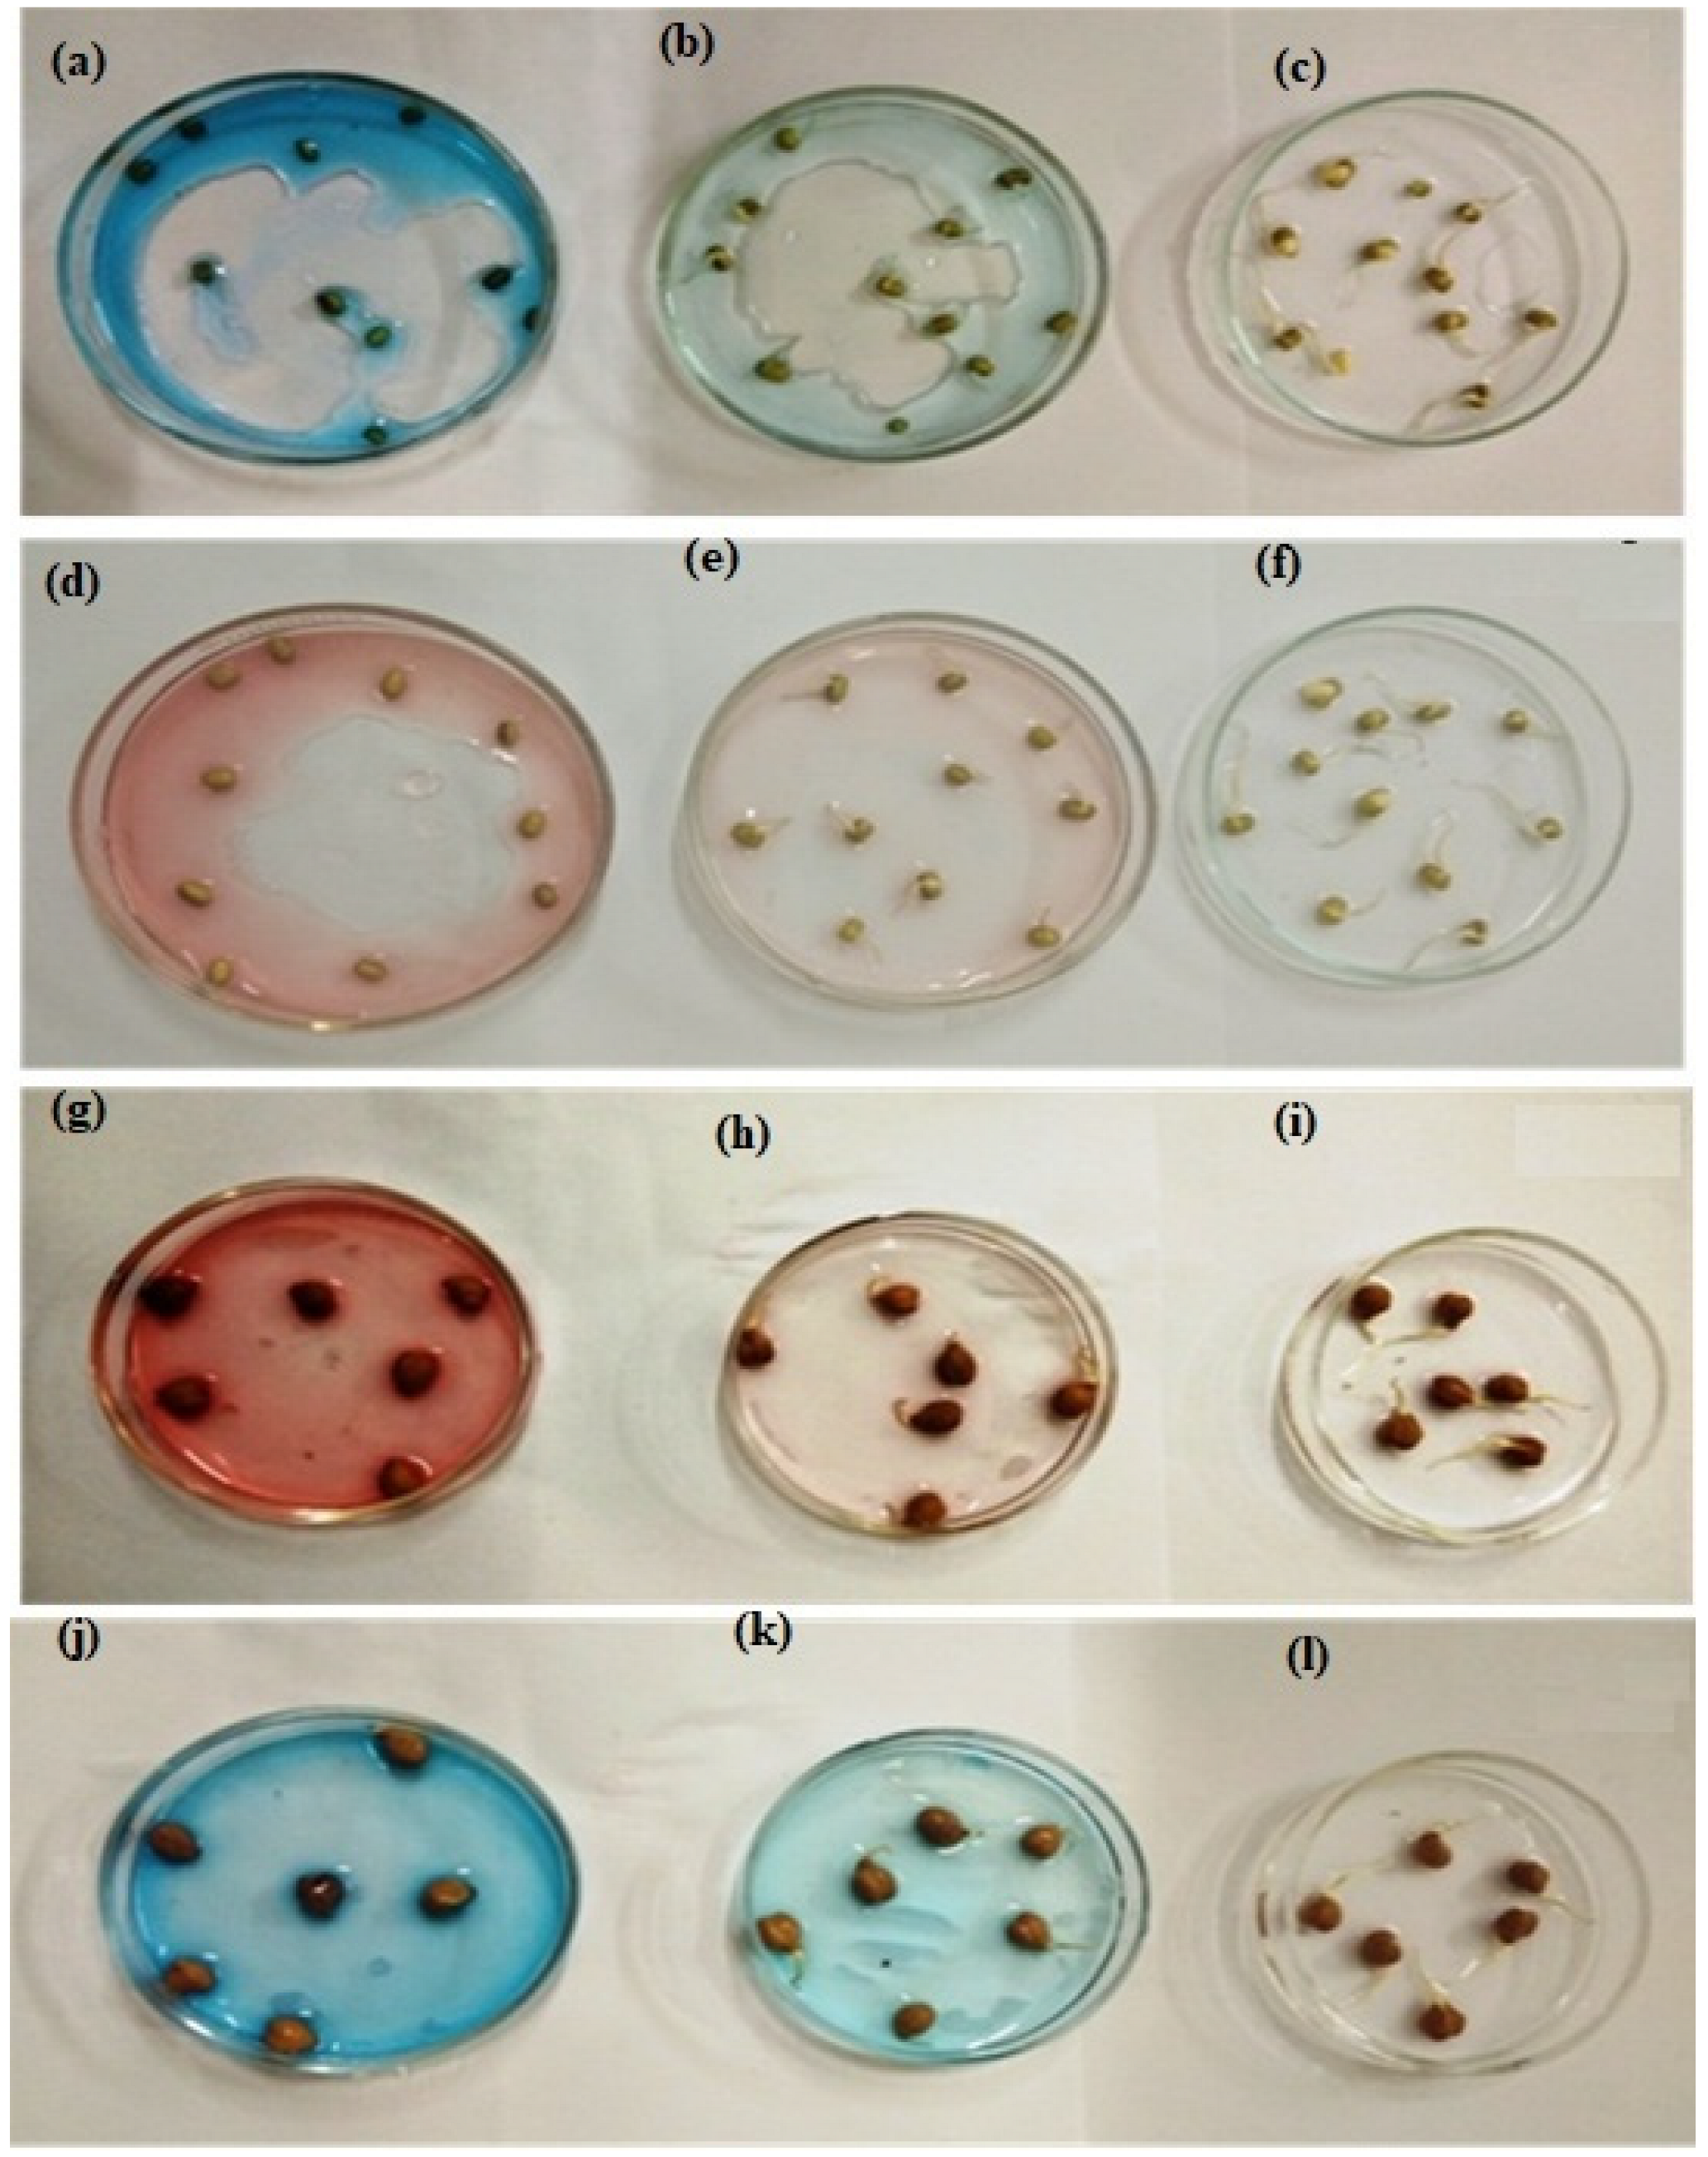
Microorganisms 11 01435 g011 Microorganisms 11 01435 g011

Live Biomass of Rigidoporus vinctus: A Sustainable Method for Decoloration and Detoxification of Dyes in Water
Abstract
1. Introduction
2. Materials and Method
2.1. Materials
2.2. Methods
2.3. Identification of Isolate
2.4. Screening for Lignin-Modifying Enzymes (LME)
2.5. Screening for Cellulolytic Enzymes
2.6. Determination of Adsorption Capacity and Removal Rate
3. Results and Discussion
3.1. Identification of Isolate
3.1.1. Morphological Identification
3.1.2. Molecular Identification
3.2. Screening for Cellulose-Degrading and Lignin-Modifying Enzyme Activity
3.3. SEM Analysis
3.4. EDS Study
3.5. FT-IR Analysis
3.6. Adsorption Studies
3.6.1. Effect of R. vinctus Dosage and Contact Time
3.6.2. Effect of Initial Dye Concentrations
3.6.3. Effect of Solution pH
3.7. Isotherm Studies
3.8. Adsorption Kinetics
3.9. Proposed Biosorption Mechanism
3.10. Toxicity Assessment
3.11. Comparative Studies
4. Conclusions
Author Contributions
Funding
Data Availability Statement
Acknowledgments
Conflicts of Interest
References
- He, K.; Chen, G.; Zeng, G.; Chen, A.; Huang, Z.; Shi, J.; Hu, L. Three-dimensional graphene supported catalysts for organic dyes degradation. Appl. Catal. B Environ. 2018, 228, 19–28. [Google Scholar] [CrossRef]
- Rasheed, T.; Bilal, M.; Nabeel, F.; Adeel, M.; Iqbal, H.M. Environmentally-related contaminants of high concern: Potential sources and analytical modalities for detection, quantification, and treatment. Environ. Int. 2019, 122, 52–66. [Google Scholar] [CrossRef]
- Ahmed, R.; Siddiqui, S.I.; Al Alwan, B.; Almesfer, M.; Khanna, M.K.; Fatima, B.; Mishra, R.; Ansari, M.A.; Oh, S. Biodegradable acid based nanocomposite-CuO-ZnO-Ni(OH)2/PA: A novel material for water cleansing. J. Clean. Prod. 2022, 341, 130860. [Google Scholar] [CrossRef]
- Yagub, M.T.; Sen, T.K.; Afroze, S.; Ang, H.M. Dye and its removal from aqueous solution by adsorption: A review. Adv. Colloid Interface Sci. 2014, 209, 172–184. [Google Scholar] [CrossRef] [PubMed]
- Ayed, L.; Mahdhi, A.; Cheref, A.; Bakhrouf, A. Decolorization and degradation of azo dye Methyl red by an isolated Sphingomonas paucimobilis: Biotoxicity and metabolites characterization. Desalination 2011, 274, 272–277. [Google Scholar] [CrossRef]
- Shukla, S.K.; Mangwani, N.; Rao, T.S.; Das, S. Biofilm-mediated bioremediation of polycyclic aromatic hydrocarbons. In Microbial Biodegradation and Bioremediation; Elsevier: Amsterdam, The Netherlands, 2014; pp. 203–232. [Google Scholar]
- Shah, I.; Sudarsan, J.S.; Shah, U.; Ramesh, S.; Sehran, M. Impact on ground water due to textile industries in Kadodara Region, Surat, Gujarat, India. In Proceedings of the 11th National Conference on Mathematical Techniques and Applications, Chennai, India, 11–12 January 2019; Volume 2112, pp. 20–177. [Google Scholar]
- Holkar, C.R.; Jadhav, A.J.; Pinjari, D.V.; Mahamuni, N.M. A critical review on textile wastewater treatments: Possible approaches A critical review on textile wastewater treatments: Possible approaches. J. Environ. Manag. 2016, 182, 351–366. [Google Scholar] [CrossRef] [PubMed]
- Siddiqui, S.I.; Ravi, R.; Rathi, G.; Tara, N.; Islam, S.U.; Chaudhry, S.A. Decolorization of textile wastewater using composite materials. In Nano Materials in the Wet Processing of Textiles; Islam, S.U., Butola, B.S., Eds.; John Wiley & Sons, Inc: Hoboken, NJ, USA, 2018; pp. 187–218. [Google Scholar]
- Malik, R.; Ramteke, D.S.; Wate, S.R. Adsorption of malachite green on groundnut shell waste based powdered activated carbon. Waste Manag. 2007, 27, 1129–1138. [Google Scholar] [CrossRef] [PubMed]
- Choudhry, A.; Sharma, A.; Siddiqui, S.I.; Ahamad, I.; Sajid, M.; Khan, T.A.; Chaudhry, S.A. Origanum vulgare manganese ferrite nanocomposite: An advanced multifunctional hybrid material for dye remediation. Environ. Res. 2023, 220, 115193. [Google Scholar] [CrossRef] [PubMed]
- Hessel, C.; Allegre, C.; Maisseu, M.; Charbit, F.; Moulin, P. Guidelines and legislation for dye house effluents. J. Environ. Manag. 2007, 83, 171–180. [Google Scholar] [CrossRef] [PubMed]
- Liang, C.Z.; Sun, S.P.; Li, F.Y.; Ong, Y.K.; Chung, T.S. Treatment of highly concentrated wastewater containing multiple synthetic dyes by a combined process of coagulation/flocculation and nanofiltration. J. Membr. Sci. 2014, 469, 306–315. [Google Scholar] [CrossRef]
- Zahrim, A.Y.; Hilal, N. Treatment of highly concentrated dye solution by coagulation/flocculations and filtration and nanofiltration. Water Resour. Ind. 2013, 3, 23–34. [Google Scholar] [CrossRef]
- Ling, S.K.; Wang, S.; Peng, Y. Oxidative degradation of dyes in water using Co2+/H2O2 and Co2+/peroxymonosulfate. J. Hazard. Mater. 2010, 178, 385–389. [Google Scholar] [CrossRef] [PubMed]
- Avlonitis, S.A.; Poulios, I.; Sotiriou, D.; Pappas, M.; Moutesidis, K. Simulated cotton dye effluents treatment and reuse by nanofiltration. Desalination 2008, 221, 259–267. [Google Scholar] [CrossRef]
- Sripiboon, S.; Suwannahong, K. Color removal by ozonation process in biological wastewater treatment from the breweries. In Proceedings of the 8th International Conference on Environment Science and Engineering (ICESE 2018), Barcelona, Spain, 11–13 March 2018; Volume 167, p. 012010. [Google Scholar]
- Eslami, A.; Yazdanbakhsh, A.R.; Momayyezi, M.H. Removal of reactive dyes from textile wastewater using sonochemical process: Effective parameters study. J. Res. Health 2015, 5, 184–192. [Google Scholar]
- Zhang, X.; Kamali, M.; Uleners, T.; Symus, J.; Zhang, S.; Liu, Z.; Costa, M.E.V.; Appels, L.; Cabooter, D.; Dewil, R. UV/TiO2/periodate system for the degradation of organic pollutants—Kinetics, mechanisms and toxicity study. Chem. Eng. J. 2022, 449, 137680. [Google Scholar] [CrossRef]
- Zhang, X.; Verbist, M.; Kamali, M.; Xue, Y.; Liu, Y.; Jin, P.; Costa, M.E.V.; Appels, L.; Cabooter, D.; Dewil, R. Activation of periodate with pinewood biochar-CuO composite for the removal of recalcitrant organic pollutants—Mechanisms and degradation products. Chem. Eng. J. 2023, 465, 142916. [Google Scholar] [CrossRef]
- Narasimharao, K.; Al-Thabaiti, S.; Rajor, H.K.; Mokhtar, M.; Alsheshri, A.; Alfaifi, S.Y.; Siddiqui, S.I.; Abdulla, N.K. Fe3O4@ date seeds powder: A sustainable nanocomposite material for wastewater treatment. J. Mater. Res. Technol. 2022, 18, 3581–3597. [Google Scholar] [CrossRef]
- Kaushik, P.; Malik, A. Fungal dye decolourization: Recent advances and future potential. Environ. Int. 2009, 35, 127–141. [Google Scholar] [CrossRef]
- Katheresan, V.; Kansedo, J.; Lau, S.Y. Efficiency of various recent wastewater dye removal methods: A review. J. Environ. Chem. Eng. 2018, 6, 4676–4697. [Google Scholar] [CrossRef]
- Sadegh, H.; Ali, G.A.; Gupta, V.K.; Makhlouf, A.S.H.; Shahryari-Ghoshekandi, R.; Nadagouda, M.N.; Megiel, E. The role of nanomaterials as effective adsorbents and their applications in wastewater treatment. J. Nanostructure Chem. 2017, 7, 1–14. [Google Scholar] [CrossRef]
- Chatterjee, S.; Guha, N.; Krishnan, S.; Singh, A.K.; Mathur, P.; Rai, D.K. Selective and recyclable Congo red dye adsorption by spherical Fe3O4 nanoparticles functionalized with 1, 2, 4, 5-benzenetetracarboxylic acid. Sci. Rep. 2020, 10, 111. [Google Scholar] [CrossRef] [PubMed]
- Moharana, A.; Kumar, A.; Thakur, A.; Vo, D.V.N.; Sharma, A.; Kumar, D. Role of nanostructured metal oxides in photocatalysis: An overview. In Nanostructured Photocatalysts; Elsevier: Amsterdam, The Netherlands, 2021; pp. 145–167. [Google Scholar]
- Jumadi, J.; Kamari, A.; Rahim, N.A.; Wong, S.T.S.; Yusoff, S.N.M.; Ishak, S.; Kumaran, S. Removal of methylene blue and congo red by magnetic chitosan nanocomposite: Characterization and adsorption studies. In Proceedings of the 6th International Conference on Research, Implementation, and Education of Mathematics and Science, Yogyakarta, Indonesia, 12–13 July 2019; Volume 1397, p. 012027. [Google Scholar]
- Athawale, A.; Bokare, A.; Singh, H.; Nguyen, V.H.; Vo, D.V.N.; Kumar, D.; Sharma, A. Synthesis of Ag2O coated TiO2 nanoparticles by sonochemically activated methods for enhanced photocatalytic activities. Top. Catal. 2020, 63, 1056–1065. [Google Scholar] [CrossRef]
- Sharma, K.; Sharma, S.; Sharma, V.; Mishra, P.K.; Ekielski, A.; Sharma, V.; Kumar, V. Methylene blue dye adsorption from wastewater using hydroxyapatite/gold nanocomposite: Kinetic and thermodynamics studies. Nanomaterials 2021, 11, 1403. [Google Scholar] [CrossRef] [PubMed]
- Osagie, C.; Othmani, A.; Ghosh, S.; Malloum, A.; Esfahani, Z.K.; Ahmadi, S. Dyes adsorption from aqueous media through the nanotechnology: A review. J. Mater. Res. Technol. 2021, 14, 2195–2218. [Google Scholar] [CrossRef]
- Hernández, P.; Santiago-Cuevas, A.; Palacios-Cabrera, C.; Thangarasu, P.; Narayanan, J.; Kaur, H.; Sharma, A. Development and applications of Ru and Ce based iron oxides as photocatalysts. Mater. Lett. 2022, 313, 131720. [Google Scholar] [CrossRef]
- Shanmugaraj, K.; Campos, C.H.; Mangalaraja, R.V.; Nandhini, K.; Aepuru, R.; Torres, C.C.; Vo, D.V.N. Gold nanoparticle–decorated earth-abundant clay nanotubes as catalyst for the degradation of phenothiazine dyes and reduction of 4-(4-nitrophenyl) morpholine. Environ. Sci. Pollut. Res. 2022, 1–12. [Google Scholar] [CrossRef]
- Dayi, B.; Kyzy, A.D.; Akdogan, H.A. Characterization of recuperating talent of white-rot fungi cells to dye-contaminated soil/water. Chin. J. Chem. Eng. 2019, 27, 634–638. [Google Scholar] [CrossRef]
- Talaiekhozani, A.; Rezania, S. Application of photosynthetic bacteria for removal of heavy metals, macro-pollutants and dye from wastewater: A review. J. Water Process Eng. 2017, 19, 312–321. [Google Scholar] [CrossRef]
- Alaguprathana, M.; Poonkothai, M. Bioremediation of textile dyeing effluent using algae–A review. J. Adv. Microbiol. 2017, 7, 1–12. [Google Scholar] [CrossRef]
- Deshmukh, R.; Khardenavis, A.A.; Purohit, H.J. Diverse metabolic capacities of fungi for bioremediation. Indian J. Microbiol. 2016, 56, 247–264. [Google Scholar] [CrossRef]
- Hou, L.; Ji, D.; Dong, W.; Yuan, L.; Zhang, F.; Li, Y.; Zang, L. The synergistic action of electro-Fenton and white-rot fungi in the degradation of lignin. Front. Bioeng. Biotechnol. 2020, 8, 99. [Google Scholar] [CrossRef] [PubMed]
- Kumar, A.; Kumar, V.; Singh, J. Role of fungi in the removal of heavy metals and dyes from wastewater by biosorption processes. In Recent Advancement in White Biotechnology through Fungi; Springer: Berlin/Heidelberg, Germany, 2019; pp. 397–418. [Google Scholar]
- Fu, Y.; Viraraghavan, T. Fungal decolorization of dye wastewaters: A review. Bioresour. Technol. 2001, 79, 251–262. [Google Scholar] [CrossRef] [PubMed]
- Senthilkumar, S.; Perumalsamy, M.; Prabhu, H.J. Decolourization potential of white-rot fungus Phanerochaete chrysosporium on synthetic dye bath effluent containing Amido black 10B. J. Saudi Chem. Soc. 2014, 18, 845–853. [Google Scholar] [CrossRef]
- Srinivasan, A.; Viraraghavan, T. Decolorization of dye wastewaters by biosorbents: A review. J. Environ. Manag. 2010, 91, 1915–1929. [Google Scholar] [CrossRef] [PubMed]
- Naghipour, D.; Taghavi, K.; Moslemzadeh, M. Removal of methylene blue from aqueous solution by Artist’s Bracket fungi: Kinetic and equilibrium studies. Water Sci. Technol. 2016, 73, 2832–2840. [Google Scholar] [CrossRef] [PubMed]
- Bouras, H.D.; Isik, Z.; Arikan, E.B.; Yeddou, A.R.; Bouras, N.; Chergui, A.; Dizge, N. Biosorption characteristics of methylene blue dye by two fungal biomasses. Int. J. Environ. Stud. 2021, 78, 365–381. [Google Scholar] [CrossRef]
- Li, H.; Liu, L.; Cui, J.; Cui, J.; Wang, F.; Zhang, F. High-efficiency adsorption and regeneration of methylene blue and aniline onto activated carbon from waste edible fungus residue and its possible mechanism. RSC Adv. 2020, 10, 14262–14273. [Google Scholar] [CrossRef]
- Abdallah, R.; Taha, S. Biosorption of methylene blue from aqueous solution by nonviable Aspergillus fumigatus. Chem. Eng. J. 2012, 195, 69–76. [Google Scholar] [CrossRef]
- Karatay, S.E.; Gul, U.D.; Donmez, G. Determination of Methylene Blue biosorption by Rhizopus arrhizus in the presence of surfactants with different chemical structures. Prep. Biochem. Biotechnol. 2014, 44, 653–662. [Google Scholar] [CrossRef]
- Cheng, M.; Zeng, G.; Huang, D.; Lai, C.; Wei, Z.; Li, N.; He, X. Combined biological removal of methylene blue from aqueous solutions using rice straw and Phanerochaete chrysosporium. Appl. Microbiol. Biotechnol. 2015, 99, 5247–5256. [Google Scholar] [CrossRef]
- Maurya, N.S.; Mittal, A.K.; Cornel, P.; Rother, E. Biosorption of dyes using dead macro fungi: Effect of dye structure, ionic strength and pH. Bioresour. Technol. 2006, 97, 512–521. [Google Scholar] [CrossRef] [PubMed]
- Bouras, H.D.; RédaYeddou, A.; Bouras, N.; Chergui, A.; Favier, L.; Amrane, A.; Dizge, N. Biosorption of cationic and anionic dyes using the biomass of Aspergillus parasiticus CBS 100926T. Water Sci. Technol. 2021, 83, 622–630. [Google Scholar] [CrossRef] [PubMed]
- Yildirim, A. Kinetic, equilibrium and thermodynamic investigations for the bio-sorption of dyes onto crosslinked Pleurotus ostreatus-based bio-composite. Int. J. Environ. Anal. Chem. 2022, 102, 5664–5679. [Google Scholar] [CrossRef]
- Ahmed, H.A.B.; Ebrahim, S.E. Removal of methylene blue and Congo red dyes by pretreated fungus biomass-equilibrium and kinetic studies. J. Adv. Res. Fluid Mech. Therm. Sci. 2020, 66, 84–100. [Google Scholar]
- Aksu, Z.; Ertugrul, S.; Donmez, G. Methylene Blue biosorption by Rhizopus arrhizus: Effect of SDS (sodium dodecylsulfate) surfactant on biosorption properties. Chem. Eng. J. 2010, 158, 474–481. [Google Scholar] [CrossRef]
- Kabbout, R.; Taha, S. Biodecolorization of textile dye effluent by biosorption on fungal biomass materials. Phys. Procedia 2014, 55, 437–444. [Google Scholar] [CrossRef]
- Islek, C.; Sinag, A.; Akata, I. Investigation of biosorption behavior of Methylene blue on Pleurotus ostreatus (Jacq.) P. Kumm. CLEAN–Soil Air Water 2008, 36, 387–392. [Google Scholar] [CrossRef]
- Sharma, P.; Singh, L.; Dilbaghi, N. Biodegradation of Orange II dye by Phanerochaete chrysosporium in simulated wastewater. J. Sci. Ind. Res. 2009, 68, 157–161. [Google Scholar]
- Levin, L.; Melignani, E.; Ramos, A.M. Effect of nitrogen sources and vitamins on ligninolytic enzyme production by some white-rot fungi. Dye decolorization by selected culture filtrates. Bioresour. Technol. 2010, 101, 4554–4563. [Google Scholar] [CrossRef]
- Niebisch, C.H.; Malinowski, A.K.; Schadeck, R.; Mitchell, D.A.; Kava-Cordeiro, V.; Paba, J. Decolorization and biodegradation of reactive blue 220 textile dye by Lentinus crinitus extracellular extract. J. Hazard. Mater. 2010, 180, 316–322. [Google Scholar] [CrossRef]
- Bankole, P.O.; Adekunle, A.A.; Govindwar, S.P. Biodegradation of a monochlorotriazine dye, Cibacron brilliant red 3B-A in solid state fermentation by wood-rot fungal consortium, Daldinia concentric and Xylaria polymorpha: Co-biomass decolorization of Cibacron brilliant red 3B-A dye. Int. J. Biol. Macromol. 2018, 120, 19–27. [Google Scholar] [CrossRef] [PubMed]
- Zhang, H.; Zhang, J.; Zhang, X.; Geng, A. Purification and characterization of a novel manganese peroxidase from white-rot fungus Cerrena unicolor BBP6 and its application in dye decolorization and denim bleaching. Process Biochem. 2018, 66, 222–229. [Google Scholar] [CrossRef]
- Rajhans, G.; Barik, A.; Sen, S.K.; Raut, S. Degradation of dyes by fungi: An insight into mycoremediation. Biotechnologia 2021, 102, 445–455. [Google Scholar] [CrossRef] [PubMed]
- Ardila-Leal, L.D.; Poutou-Pinales, R.A.; Pedroza-Rodriguez, A.M.; Quevedo-Hidalgo, B.E. A brief history of colour, the environmental impact of synthetic dyes and removal by using laccases. Molecules 2021, 26, 3813. [Google Scholar] [CrossRef] [PubMed]
- Lellis, B.; Favaro-Polonio, C.Z.; Pamphile, J.A.; Polonio, J.C. Effects of textile dyes on health and the environment and bioremediation potential of living organisms. Biotechnol. Res. Innov. 2019, 3, 275–290. [Google Scholar] [CrossRef]
- Dhankhar, R.; Hooda, A. Fungal biosorption–an alternative to meet the challenges of heavy metal pollution in aqueous solutions. Environ. Technol. 2011, 32, 467–491. [Google Scholar] [CrossRef]
- Chaudhary, S.; Sharma, P.; Kumar, R. Hydroxyapatite doped CeO2 nanoparticles: Impact on biocompatibility and dye adsorption properties. RSC Adv. 2016, 6, 62797–62809. [Google Scholar] [CrossRef]
- Kumar, R.; Negi, S.; Sharma, P.; Prasher, I.B.; Chaudhary, S.; Dhau, J.S.; Umar, A. Wastewater cleanup using Phlebia acerina fungi: An insight into mycoremediation. J. Environ. Manag. 2018, 228, 130–139. [Google Scholar] [CrossRef]
- Moller, E.M.; Bahnweg, G.; Sandermann, H.; Geiger, H.H. A simple and efficient protocol for isolation of high molecular weight DNA from filamentous fungi, fruit bodies, and infected plant tissues. Nucleic Acids Res. 1992, 20, 6115. [Google Scholar] [CrossRef]
- Singh, G.; Dwivedi, S.K. Decolorization and degradation of Direct Blue-1 (Azo dye) by newly isolated fungus Aspergillus terreus GS28, from sludge of carpet industry. Environ. Technol. Innov. 2020, 18, 100751. [Google Scholar] [CrossRef]
- Archibald, F.S. A new assay for lignin-type peroxidases employing the dye azure B. Appl. Environ. Microbiol. 1992, 58, 3110–3116. [Google Scholar] [CrossRef] [PubMed]
- Falade, A.O.; Eyisi, O.A.; Mabinya, L.V.; Nwodo, U.U.; Okoh, A.I. Peroxidase production and ligninolytic potentials of fresh water bacteria Raoultella ornithinolytica and Ensifer adhaerens. Biotechnol. Rep. 2017, 16, 12–17. [Google Scholar] [CrossRef]
- Pointing, S.B. Qualitative methods for the determination of lignocellulolytic enzyme production by tropical fungi. Fungal Divers. 1999, 2, 17–33. [Google Scholar]
- Dhiman, N.; Jasrotia, T.; Sharma, P.; Negi, S.; Chaudhary, S.; Kumar, R. Immobilization interaction between xenobiotic and Bjerkandera adusta for the biodegradation of atrazine. Chemosphere 2020, 257, 127060. [Google Scholar] [CrossRef]
- Tara, N.; Siddiqui, S.I.; Bach, Q.V.; Chaudhry, S.A. Reduce graphene oxide-manganese oxide-black cumin based hybrid composite (rGO-MnO2/BC): A novel material for water remediation. Mater. Today Commun. 2020, 25, 101560. [Google Scholar] [CrossRef]
- Grassi, P.; Reis, C.; Drumm, F.C.; Georgin, J.; Tonato, D.; Escudero, L.B.; Dotto, G.L. Biosorption of crystal violet dye using inactive biomass of the fungus Diaporthe schini. Water Sci. Technol. 2019, 79, 709–717. [Google Scholar] [CrossRef]
- Dhiman, N.; Chaudhary, S.; Singh, A.; Chauhan, A.; Kumar, R. Sustainable degradation of pharmaceutical waste using different fungal strains: Enzyme induction, kinetics and isotherm studies. Environ. Technol. Innov. 2022, 25, 102156. [Google Scholar] [CrossRef]
- Gupta, B.S.; Jelle, B.P.; Hovde, P.J.; Holme, J. Characterization of wood mould fungi by FTIR—A valuable step for prediction of initiation of decay. In Proceedings of the 12th DBMC International Conference on Durability of Building Materials and Components, Porto, Portugal, 12 April 2011; pp. 1019–1027. [Google Scholar]
- Liang, J.; Xia, J.; Long, J. Biosorption of methylene blue by nonliving biomass of the brown macroalga Sargassum hemiphyllum. Water Sci. Technol. 2017, 76, 1574–1583. [Google Scholar] [CrossRef] [PubMed]
- Gecgel, U.; Ozcan, G.; Gurpınar, G.C. Removal of methylene blue from aqueous solution by activated carbon prepared from pea shells (Pisum sativum). J. Chem. 2013, 2013, 614083. [Google Scholar] [CrossRef]
- Mondal, N.K.; Kar, S. Potentiality of banana peel for removal of Congo red dye from aqueous solution: Isotherm, kinetics and thermodynamics studies. Appl. Water Sci. 2018, 8, 157. [Google Scholar] [CrossRef]
- Vadivelan, V.; Kumar, K.V. Equilibrium, kinetics, mechanism, and process design for the sorption of methylene blue onto rice husk. J. Colloid Interface Sci. 2005, 286, 90–100. [Google Scholar] [CrossRef] [PubMed]
- Abd El-Latif, M.M.; Ibrahim, A.M. Adsorption, kinetic and equilibrium studies on removal of basic dye from aqueous solutions using hydrolyzed oak sawdust. Desalin. Water Treat. 2009, 6, 252–268. [Google Scholar] [CrossRef]
- Lafi, R.; Montasser, I.; Hafiane, A. Adsorption of Congo red dye from aqueous solutions by prepared activated carbon with oxygen-containing functional groups and its regeneration. Adsorpt. Sci. Technol. 2019, 37, 160–181. [Google Scholar] [CrossRef]
- Fatima, B.; Alwan, B.A.; Siddiqui, S.I.; Ahmad, R.; Almesfer, M.; Khanna, M.K.; Mishra, R.; Ravi, R.; Oh, S. Facile Synthesis of Cu-Zn Binary Oxide Coupled Cadmium Tungstate (Cu-ZnBO-Cp-CT) with Enhanced Performance of Dye Adsorption. Water 2021, 13, 3287. [Google Scholar] [CrossRef]
- Nanthakumar, K.; Karthikeyan, K.; Lakshmanaperumalsamy, P. Investigation on biosorption of Reactive Blue 140 by dead biomass of Aspergillus niger HM11: Kinetics and isotherm studies. Glob. J. Biotechnol. Biochem. 2009, 4, 169–178. [Google Scholar]
- Iqbal, M.; Saeed, A. Biosorption of reactive dye by loofa sponge-immobilized fungal biomass of Phanerochaete chrysosporium. Process Biochem. 2007, 42, 1160–1164. [Google Scholar] [CrossRef]
- Mustafa, M.M.; Jamal, P.; Alkhatib, M.F.; Mahmod, S.S.; Jimat, D.N.; Ilyas, N.N. Panus tigrinus as a potential biomass source for Reactive Blue decolorization: Isotherm and kinetic study. Electron. J. Biotechnol. 2017, 26, 7–11. [Google Scholar] [CrossRef]
- Siddiqui, S.I.; Chaudhry, S.A. Nanohybrid composite Fe2O3-ZrO2/BC for inhibiting the growth of bacteria and adsorptive removal of arsenic and dyes from water. J. Clean. Prod. 2019, 223, 849–868. [Google Scholar] [CrossRef]
- Bayramoglu, G.; Arica, M.Y. Adsorption of Congo Red dye by native amine and carboxyl modified biomass of Funalia trogii: Isotherms, kinetics and thermodynamics mechanisms. Korean J. Chem. Eng. 2018, 35, 1303–1311. [Google Scholar] [CrossRef]
- Hameed, B.H.; Din, A.M.; Ahmad, A.L. Adsorption of methylene blue onto bamboo-based activated carbon: Kinetics and equilibrium studies. J. Hazard. Mater. 2007, 141, 819–825. [Google Scholar] [CrossRef]
- Cresnar, B.; Petric, S. Cytochrome P450 enzymes in the fungal kingdom. Biochim. Acta (BBA)-Proteins Proteom. 2011, 1814, 29–35. [Google Scholar] [CrossRef] [PubMed]
- Dhananasekaran, S.; Palanivel, R.; Pappu, S. Adsorption of methylene blue, bromophenol blue, and coomassie brilliant blue by α-chitin nanoparticles. J. Adv. Res. 2016, 7, 113–124. [Google Scholar] [CrossRef]
- Alzahrani, E. Gum Arabic-coated magnetic nanoparticles for methylene blue removal. Int. J. Innov. Res. Sci. Eng. Technol. 2014, 3, 15118–15129. [Google Scholar] [CrossRef]
- Hua, S.; Yu, X.; Li, F.; Duan, J.; Ji, H.; Liu, W. Hydrogen titanatenanosheets with both adsorptive and photocatalytic properties used for organic dyes removal. Colloids Surf. A Physicochem. Eng. Asp. 2017, 516, 211–218. [Google Scholar] [CrossRef]
- Zhang, Z.; Kong, J. Novel magnetic Fe3O4@ C nanoparticles as adsorbents for removal of organic dyes from aqueous solution. J. Hazard. Mater. 2011, 193, 325–329. [Google Scholar] [CrossRef]
- Dashamiri, S.; Ghaedi, M.; Asfaram, A.; Zare, F.; Wang, S. Multi-response optimization of ultrasound assisted competitive adsorption of dyes onto Cu(OH)2-nanoparticle loaded activated carbon: Central composite design. Ultrason. Sonochem. 2017, 34, 343–353. [Google Scholar] [CrossRef]
- Liang, Z.; Zhao, Z.; Sun, T.; Shi, W.; Cui, F. Enhanced adsorption of the cationic dyes in the spherical CuO/meso-silica nano composite and impact of solution chemistry. J. Colloid Interface Sci. 2017, 485, 192–200. [Google Scholar] [CrossRef]
- Siddiqui, S.I.; Rathi, G.; Chaudhry, S.A. Acid washed black cumin seed powder preparation for adsorption of methylene blue dye from aqueous solution: Thermodynamic, kinetic and isotherm studies. J. Mol. Liq. 2018, 264, 275–284. [Google Scholar] [CrossRef]
- Siddiqui, S.I.; Chaudhry, S.A. Nigella sativa plant based nanocomposite-MnFe2O4/BC: An antibacterial material for water purification. J. Clean. Prod. 2018, 200, 996–1008. [Google Scholar] [CrossRef]
- Reddy, M.C.S.; Nirmala, V.; Ashwini, C. Bengal gram seed husk as an adsorbent for the removal of dye from aqueous solutions-batch studies. Arab. J. Chem. 2017, 10, 2554–2566. [Google Scholar] [CrossRef]
- Fu, Y.; Viraraghavan, T. Removal of Congo red from an aqueous solution by fungus Aspergillus niger. Adv. Environ. Res. 2002, 7, 239–247. [Google Scholar] [CrossRef]
- Hu, Z.; Chen, H.; Ji, F.; Yuan, S. Removal of Congo Red from aqueous solution by cattail root. J. Hazard. Mater. 2010, 173, 292–297. [Google Scholar] [CrossRef] [PubMed]
- Tor, A.; Cengeloglu, Y. Removal of congo red from aqueous solution by adsorption onto acid activated red mud. J. Hazard. Mater. 2006, 138, 409–415. [Google Scholar] [CrossRef] [PubMed]
- Kaur, H. Kinetic and Isotherm studies of Congo red adsorption from aqueous solution by biowaste material. Chem. Sci. Trans. 2014, 3, 1300–1309. [Google Scholar]
- Dil, E.A.; Ghaedi, M.; Asfaram, A.; Bazrafshan, A.A. Ultrasound wave assisted adsorption of congo red using gold-magnetic nanocomposite loaded on activated carbon: Optimization of process parameters. Ultrason. Sonochem. 2018, 46, 99–105. [Google Scholar] [CrossRef]
- Arslan, M. Use of 1, 6-diaminohexane-functionalized glycidyl methacrylate-g-poly (ethylene terephthalate) fiber for removal of acidic dye from aqueous solution. Fibers Polym. 2010, 11, 177–184. [Google Scholar] [CrossRef]

| Order | Biosorbent | MB Adsorption Capacity (mg/g) | Reference |
|---|---|---|---|
| 1. | Artist’s bracket fungi | 100.0 | [42] |
| 2. | Aspergillus carbonarius Penicillium glabrum | 21.88 16.67 | [43] |
| 3. | Edible fungus residue activated carbon | 662.25 | [44] |
| 4. | Aspergillus fumigatus (dead biomass) | 125.0 | [45] |
| 5. | Rhizopusarrhizus (dead biomass) | 471.5 | [46] |
| 6. | Rice straw ferment with Phanerochete chrysosporium | 51.4 | [47] |
| 7. | Dead biomass of Fomesfomentarius and Phellinusigniarius | 204–232 | [48] |
| 8. | Dried biomass of Aspergillus parasiticus | 63.29 | [49] |
| 9. | Pleurotus ostreatus-based biocomposite | 40.11 | [50] |
| 10. | Spent mushroom waste | 239.81 | [51] |
| 11. | Dried biomass of Rhizopus arrhizus | 370.3 | [52] |
| Order | Fungus | Dye | Removal Efficiency (%) | Experimental Conditions | Mechanism | Contact Time | Reference |
|---|---|---|---|---|---|---|---|
| 1. | Sphingomonaspaucimobilis | Methyl red | 99.63 | pH 9.0 Temp. 30 °C Conc. 750 mg/L Shaking conditions | Enzyme production Biodegradation | 10 h | [5] |
| 2. | Trametes versicolor | Methyl red Reactive red 220 | 91.0 80.0 | Conc. 75 mg/L Conc. 50 mg/L | Laccase and MnP | 8 days | [33] |
| 3. | Applanatum lucidum | MB | 99.8 | Initial conc. 25 mg/L pH 9.0 Biosorbent dose 0.15 g | Adsorption | [42] | |
| 4. | Aspergillus fumigates | MB | 90.0 | Initial conc. 12 mg/L pH 7–13 Temp. 20–22 °C | 120 min | [53] | |
| 5. | Pleurotus ostreatus | MB | 99.0 | Initial conc. 70 mg/L pH 11 Biosorbent dose 0.1 g/L | Biosorption | 24 h | [54] |
| 6. | Phanerochaete chrysosporium | Orange II | 85.0 | Initial conc. 100 mg/L pH 5.0 Temp. 28–30 °C RPM 150 | Ligninolytic enzymes | 5 days | [55] |
| 7. | Trametes villosa, Trametes trogii and Coriolus versicolor | Gentian violet Xylidine CR Malachite green Remazol brilliant blue R Indigo carmine Anthraquinone blue | 13.0 23.0 40.0 46.0 82.0 94.0 95.0 | Initial conc. 6.1 mg/L Initial conc. 12.8 mg/L Initial conc. 58.1 mg/L Initial conc. 7.0 mg/L Initial conc. 188.8 mg/L Initial conc. 23.4 mg/L Initial conc. 250 mg/L pH 4.5 Temp. 30 °C | Laccase and manganese peroxidase (MnP) | 30 min | [56] |
| 8. | Lentinuscrinitus | Reactive blue 220 | 95.0 | pH 5.5 Temp. 28 °C Conc. 0.1 g/L | Biodegradation | 10 days | [57] |
| 9. | Daldinia concentric Xylariapolymorpha | Cibracron brilliant red 3B | - | Conc. 50 mg/L pH 4.5 Temp. 30 °C Static and shaking (150 rpm) | Laccase | 5 days | [58] |
| 10. | Cerrena unicolor | CR Methyl orange Remazol brilliant blue R Bromophenol blue Crystal violet | 53.9 77.6 81.0 62.2 80.9 | pH 4.5 Temp. 30 °C Conc. 100 mg/L | MnP | 12 h 12 h 5 h 12 h 24 h | [59] |
| Order | Element | wt.% of Fungus | wt.% of Fungus after Adsorption of MB | wt.% of Fungus after Adsorption of CR |
|---|---|---|---|---|
| 1. | Oxygen | 51.55 | 46.41 | 46.93 |
| 2. | Carbon | 44.85 | 47.25 | 47.81 |
| 3. | Phosphorus | 0.02 | - | - |
| 4. | Calcium | 0.20 | - | - |
| 5. | Nitrogen | 3.38 | 6.13 | 4.79 |
| 6. | Sulfur | - | 0.12 | 0.42 |
| 7. | Chlorine | - | 0.09 | - |
| 8. | Sodium | - | - | 0.05 |
| Order | Pollutants | Langmuir | Freundlich | |||||
|---|---|---|---|---|---|---|---|---|
| Qo (mg/g) | b (L/mg) | RL | R2 | kF (mg/g) | N | R2 | ||
| 1. | MB | 80.6 | 0.177 | 0.35 | 0.998 | 13.9 | 1.76 | 0.975 |
| 2. | CR | 54.0 | 0.124 | 0.44 | 0.995 | 16.7 | 1.77 | 0.977 |
| Order | Parameters | Pseudo-First-Order | Pseudo-Second-Order | ||||
|---|---|---|---|---|---|---|---|
| k1 1/h | Qe (cal) mg/g | R2 | k2 | Qe (cal) mg/g | R2 | ||
| 1. | MB | Qe (Exp.) = ~16.0 mg/g | Qe (Exp.) = ~16.0 mg/g | ||||
| 0.0002 | 2.6 | 0.948 | 0.0006 | 16.3 | 0.998 | ||
| 2. | CR | Qe (Exp.) = ~14.0 mg/g | Qe (Exp.) = ~14.0 mg/g | ||||
| 0.90 | 2.2 | 0.983 | 0.001 | 14.9 | 0.999 | ||
| Order | Adsorbent | MB Adsorption Capacity (mg/g) | Reference |
|---|---|---|---|
| 1. | Fe2O3-ZrO2/BC | 38.10 | [86] |
| 2. | α-chitin nanoparticles | 06.90 | [90] |
| 3. | Gum-arabic-coated Fe3O4 | 14.30 | [91] |
| 4. | Hydrogen titanate nanosheets | 81.50 | [92] |
| 5. | Fe3O4@C nanoparticles | 44.38 | [93] |
| 6. | Cu(OH)2-NP-AC | 32.90 | [94] |
| 7. | CuO/MCM-41 | 65.70 | [95] |
| 8. | Acid-washed black cumin | 73.53 | [96] |
| 9. | MnFe2O4/BC | 10.07 | [97] |
| 10. | Rigidoporus vinctus | 80.6 | This study |
| CR adsorption capacity (mg/g) | Reference | ||
| 11. | Banana peel | 1.72 | [78] |
| 12. | Bengal gram seed husk | 41.66 | [98] |
| 13. | Asprgillus niger | 14.16 | [99] |
| 14. | Cattail root | 38.79 | [100] |
| 15. | Activated red mud | 7.087 | [101] |
| 16. | Biowaste material | 18.45 | [102] |
| 17. | Au-Fe3O4-NCs-AC | 43.88 | [103] |
| 18. | Glycidyl methacrylate-g-poly (ethylene terephthalate fiber | 16.60 | [104] |
| 19. | Rigidoporus vinctus | 54.0 | This study |
Disclaimer/Publisher’s Note: The statements, opinions and data contained in all publications are solely those of the individual author(s) and contributor(s) and not of MDPI and/or the editor(s). MDPI and/or the editor(s) disclaim responsibility for any injury to people or property resulting from any ideas, methods, instructions or products referred to in the content. |
© 2023 by the authors. Licensee MDPI, Basel, Switzerland. This article is an open access article distributed under the terms and conditions of the Creative Commons Attribution (CC BY) license (https://creativecommons.org/licenses/by/4.0/).
Share and Cite
Shehnaz; Prasher, I.B.; Ahmad, N.; Ahmed, M.; Raghuwanshi, S.; Kumar, V.; Siddiqui, S.I.; Oh, S. Live Biomass of Rigidoporus vinctus: A Sustainable Method for Decoloration and Detoxification of Dyes in Water. Microorganisms 2023, 11, 1435. https://doi.org/10.3390/microorganisms11061435
Shehnaz, Prasher IB, Ahmad N, Ahmed M, Raghuwanshi S, Kumar V, Siddiqui SI, Oh S. Live Biomass of Rigidoporus vinctus: A Sustainable Method for Decoloration and Detoxification of Dyes in Water. Microorganisms. 2023; 11(6):1435. https://doi.org/10.3390/microorganisms11061435
Chicago/Turabian StyleShehnaz, I. B. Prasher, Naushad Ahmad, Mukhtar Ahmed, Shivani Raghuwanshi, Vijay Kumar, Sharf Ilahi Siddiqui, and Seungdae Oh. 2023. "Live Biomass of Rigidoporus vinctus: A Sustainable Method for Decoloration and Detoxification of Dyes in Water" Microorganisms 11, no. 6: 1435. https://doi.org/10.3390/microorganisms11061435
APA StyleShehnaz, Prasher, I. B., Ahmad, N., Ahmed, M., Raghuwanshi, S., Kumar, V., Siddiqui, S. I., & Oh, S. (2023). Live Biomass of Rigidoporus vinctus: A Sustainable Method for Decoloration and Detoxification of Dyes in Water. Microorganisms, 11(6), 1435. https://doi.org/10.3390/microorganisms11061435

